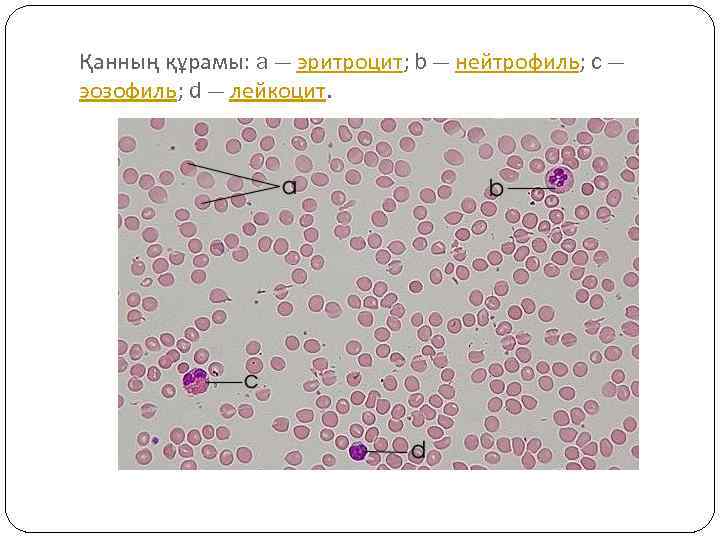
Қанның құрамы: a — эритроцит; b — нейтрофиль; c — эозофиль; d — лейкоцит.

1178_an_analizi.pptx
- Количество слайдов: 7

Қанның жалпы анализі

Қан Ересек адам ағзасында шамамен бес литр қан болады. Қан — ағзадағы дәнекер тканінің бір түрі. Оның негізгі бөлігі жасуша аралық сұйық зат — плазмадан құралады. Плазмадан қан жасушалары — эритроциттер мен лейкоциттер және қан пластинкалары — тромбоциттер болады. Тромбоциттер сүйектің кемік майындағы жасушалардан түзіледі. Олардың жетілуі, қорға жиналып, бұзылуы басқа мүшелерде өтеді. Плазма негізінде еріген органикалық және бейорганикалық заттары бар судан тұрады. Плазма құрамының өзгеруі ағза үшін өте қауіпті. Қанға үздіксіз көптеген заттардың қосылуына қарамастан, плазманың құрамы өзгермейді. Плазмадаға артық заттар зәр шығару мүшелері арқылы шығарылады: қан өкпеде көмірқышқыл газынан, ал бүйректе — судың артық мөлшері мен онда еріген минералды тұздардан арылады
Қанның құрамы: a — эритроцит; b — нейтрофиль; c — эозофиль; d — лейкоцит.

Жалпы қан анализін тапсыруға дайындық. Қанды аш қарынға тапсыру керек, тек су ішуге ғана болады. Соңғы тамақ ішкен уақыт аралығы 8 сағаттан кем болмау керек. Мүмкіндік болса, қанды тапсыратын алдын дәрілік заттарды қабылдамау керек. Қанды тапсыратын алдын бір күні бұрын майлы және қуырылған тамақтар, ішімдік қабылдауға болмайды. Ауыр физикалық жүктемелерді шектеу керек.

Веноздық қан алу

Микрореакция

Қалыпты жағдайдағы қан көрсеткіштері
1178_an_analizi.pptx